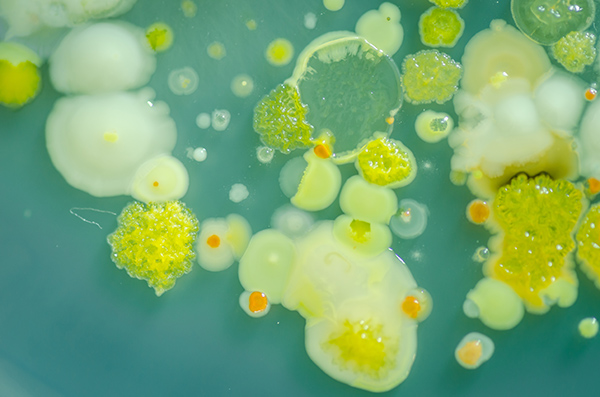

εξαρτήσεις
Το κάπνισμα αναφέρεται στη διαδικασία καύσης μιας ουσίας και εισπνοή του καπνού εντός των πνευμόνων. Ο καπνός του τσιγάρου περιέχει όχι μόνο πτητικά μέρη, αλλά και υγρά και μικρο-σωματίδια. Συνολικά 4800 διαφορετικές ενώσεις βρίσκονται στο καπνό του τσιγάρου, εκ των οποίων πολλά έχουν ταξινομηθεί ως επικίνδυνα για την ανθρώπινη υγεία, π.χ. θεωρούνται καρκινογόνα.
Μια πιο προσεκτική ματιά της αέριας φάσης του, δείχνει ότι αποτελείται κυρίως από άζωτο (Ν2), οξυγόνο (Ο2), μονοξείδιο του άνθρακα (CO) και διοξείδιο του άνθρακα (CO2). Το μονοξείδιο του άνθρακα είναι πολύ τοξικό λόγω της υψηλής συγγένειας του με την αιμοσφαιρίνη, μια πρωτεΐνη που βρίσκεται στο αίμα μας. Η αιμοσφαιρίνη είναι υπεύθυνη για τη μεταφορά μορίων οξυγόνου σε όλα τα μέρη του σώματός μας, αλλά δεδομένου ότι η συγγένεια με το μονοξείδιο του άνθρακα είναι μεγαλύτερη, αναγκάζεται να μεταφέρει λιγότερο οξυγόνο. Αυτό οδηγεί σε έλλειψη βασικού οξυγόνου και επακόλουθη βλάβη σε άλλους ιστούς, όπως ο εγκέφαλος.
Η βλαβερή επίδραση του καπνού δεν αποδίδεται μόνο στην αέρια φάση, αλλά και στα μικροσωματίδια. Για παράδειγμα, αρωματικές και ετεροκυκλικές αμίνες - παράγωγα της αμμωνίας - φαίνεται να είναι αιτία του καρκίνου της ουροδόχου κύστης. Ακόμα και μη-παθογόνα σωματίδια μπορούν να βλάψουν τους πνεύμονές μας, δεδομένου ότι ερεθίσει τις πνευμονικές κυψελίδες, που τους καθιστά πιο επιρρεπείς σε λοιμώξεις.
Επιπλέον, ο καπνός του τσιγάρου θεωρείται επικίνδυνος λόγω του στοιχείου της νικοτίνης, στην οποία οι άνθρωποι εθίζονται. Αυτό συνδέεται με έναν υποδοχέα στο νευρικό μας σύστημα και είναι εξαιρετικά εθιστικό, γεγονός που καθιστά δύσκολο για τους ανθρώπους να σταματήσουν το κάπνισμα.
Μια πιο προσεκτική ματιά της αέριας φάσης του, δείχνει ότι αποτελείται κυρίως από άζωτο (Ν2), οξυγόνο (Ο2), μονοξείδιο του άνθρακα (CO) και διοξείδιο του άνθρακα (CO2). Το μονοξείδιο του άνθρακα είναι πολύ τοξικό λόγω της υψηλής συγγένειας του με την αιμοσφαιρίνη, μια πρωτεΐνη που βρίσκεται στο αίμα μας. Η αιμοσφαιρίνη είναι υπεύθυνη για τη μεταφορά μορίων οξυγόνου σε όλα τα μέρη του σώματός μας, αλλά δεδομένου ότι η συγγένεια με το μονοξείδιο του άνθρακα είναι μεγαλύτερη, αναγκάζεται να μεταφέρει λιγότερο οξυγόνο. Αυτό οδηγεί σε έλλειψη βασικού οξυγόνου και επακόλουθη βλάβη σε άλλους ιστούς, όπως ο εγκέφαλος.
Η βλαβερή επίδραση του καπνού δεν αποδίδεται μόνο στην αέρια φάση, αλλά και στα μικροσωματίδια. Για παράδειγμα, αρωματικές και ετεροκυκλικές αμίνες - παράγωγα της αμμωνίας - φαίνεται να είναι αιτία του καρκίνου της ουροδόχου κύστης. Ακόμα και μη-παθογόνα σωματίδια μπορούν να βλάψουν τους πνεύμονές μας, δεδομένου ότι ερεθίσει τις πνευμονικές κυψελίδες, που τους καθιστά πιο επιρρεπείς σε λοιμώξεις.
Επιπλέον, ο καπνός του τσιγάρου θεωρείται επικίνδυνος λόγω του στοιχείου της νικοτίνης, στην οποία οι άνθρωποι εθίζονται. Αυτό συνδέεται με έναν υποδοχέα στο νευρικό μας σύστημα και είναι εξαιρετικά εθιστικό, γεγονός που καθιστά δύσκολο για τους ανθρώπους να σταματήσουν το κάπνισμα.
νόμοι: Το κάπνισμα σκοτώνει 6 εκατομμύρια ανθρώπους κάθε χρόνο. Ως εκ τούτου, οι νόμοι που απαγορεύουν το κάπνισμα θα σώσουν όχι μόνο τους καπνιστές, αλλά και 500.000 ανθρώπους που πεθαίνουν εξαιτίας της έκθεσης στον καπνό ως παθητικοί καπνιστές. Οι άνθρωποι που πλήττονται από ασθένειες που σχετίζονται με το κάπνισμα κοστίζουν στις υγειονομικές αρχές εκατομμύρια ευρώ κάθε χρόνο, και μερικοί άνθρωποι πιστεύουν ότι οι καπνιστές θα πρέπει να αντιμετωπίζονται διαφορετικά από πλευράς των δικαιωμάτων τους στην ιατρική περίθαλψη.
καπνός μαριχουάνας: Παρά το γεγονός ότι η μαριχουάνα δεν περιέχει το στοιχείο της εθιστικής νικοτίνης, παρ’όλα αυτά εξακολουθεί να είναι πολύ επιβλαβές όταν καπνίζεται λόγω των πολλών παθογόνων ουσιών. Για παράδειγμα, τα επίπεδα ορισμένων αρωματικών αμινών βρέθηκε να είναι τουλάχιστον τρεις φορές υψηλότερη από ό, τι στον καπνό του τσιγάρου.
υποστήριξη για τη διακοπή του καπνίσματος: Η νικοτίνη προκαλεί εθισμό. Ως εκ τούτου, οι άνθρωποι χρειάζονται συχνά βοήθεια για να σταματήσουν τελείως το κάπνισμα.
Ο καπνός του τσιγάρου, Τσιγάρο, Κίνδυνοι για την υγεία που σχετίζονται κάπνισμα, Καπνός μαριχουάνας, Εθισμός
Related Topics

Xρυσή τομή
Η Xρυσή Τομή επιτυγχάνεται όταν μια γραμμή διαιρείται στο μεγαλύτερο τμήμα Α και το μικρότερο τμήμα Β τέτοια ώστε Α + Β διαιρεμένο από το Α ισούται...
READ MORE
ακαθαρσίες
Αναρωτηθήκατε ποτέ πόσο καθαρή είναι η αίθουσα της τάξης σας, έστω και αν φαίνεται καθαρή με γυμνό μάτι? Μικροοργανισμοί (βακτήρια, μύκητες, ιοί) μ...
READ MORE

ανοιχτή θεματολογία Stem
Οι Φυσικές επιστημες, Tεχνολογία, Mηχανική και Mαθηματικά (STEM – Science Technology Engineering Mathematics) καλύπτουν πολλά διαφορετικά και ταχέω...
READ MORE

βιονική
Ο όρος «βιονικός» σημαίνει μια συγκεκριμένη κατανόηση των αρχών στην τεχνολογία που είναι «ανάλογος το φυσικού κόσμου» των φυτών και των ζώων. Βασι...
READ MORE

βιότοπος: ζωη στο νερο
Ένας βιότοπος, ορίζεται ως ο συνδυασμός της φυσικής κατοικίας και των ζωντανών οργανισμών που ζουν στη περιοχή. Ακόμα και ο υδάτινος κόσμος έχει το...
READ MORE

γιατί ο ουρανός είναι μπλέ;
Η όραση του χρώματος είναι η ικανότητα ενός οργανισμού να διακρίνει αντικείμενα με βάση τα μήκη κύματος (ή συχνότητες) του φωτός που αντανακλούν, ε...
READ MORE

διαδικτυακός εκφοβισμός
Με την ανάπτυξη και χρήση της τεχνολογίας στην καθημερινή μας ζωή έρχονται επίσης μαζί και αρνητικές επιπτώσεις. Ο Διαδικτυακός εκφοβισμός (Cyberbu...
READ MORE

διαδίκτυο
Το διαδίκτυο είναι ένα παγκόσμιο δίκτυο που συνδέει πολλαπλές συσκευές (συμπεριλαμβανομένων υπολογιστών, κινητών τηλεφώνων, παιχνιδοκονσόλων, table...
READ MORE

η ζωή στον πλανήτη γη
Βιοποικιλότητα (ή "βιολογική ποικιλότητα") είναι ένα προϊόν της εξέλιξης, η οποία έφερε στο προσκήνιο και συνεχίζει να αναπτύσσει μια ποικιλία πληθ...
READ MORE